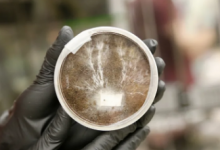

火星的水富含矿物质和咸味
目前,地球是宇宙中存在生命的唯一已知位置。今年,诺贝尔物理学奖授予了三位天文学家,他们在将近20年前证明了行星是太阳系以外恒星周围的

目前,地球是宇宙中存在生命的唯一已知位置。今年,诺贝尔物理学奖授予了三位天文学家,他们在将近20年前证明了行星是太阳系以外恒星周围的

印度天文学家对一个称为NGC 1960的年轻开放星团进行了全面的光度学,运动学和变异性研究。研究结果为该星团及其成员恒星的性质提供了更多

由欧洲航天局的银河系强国盖亚(Gaia)于三年前发起的为期500天的全球观测运动,对双星系统提供了空前的见解,这些双星系统导致了一颗甚至更

欧洲联盟周二宣布为阿丽亚娜6号火箭发射器和中小型太空技术公司提供2亿欧元(2 22亿美元)的资金。一半的钱是用于新的Ariane 6重型发射器计

经过数月的紧张不安的模拟培训,该培训组已经看到控制团队演示了一系列出现问题的场景,任务控制几乎是绿色的发射。2月6日(CET),太阳轨道

天体物理学家凯瑟琳·阿特维格(Kathrin Altwegg)的领导下,伯尔尼大学的研究人员找到了一个解释,以解释为什么以前在彗星的雾状覆盖物中仅

磷是地球上所有生物的基本元素之一。它与碳,氢,氮,氧和硫一起被认为是生命的关键成分之一。一直以来,科学家一直对它如何到达地球感到困

通过非热电子束传播通过太阳日冕和行星际空间会产生III型太阳无线电脉冲。在动态频谱中,太阳III型无线电脉冲的通量在给定频率下具有上升和

1月17日,GSAT-30与法雷亚圭亚那库鲁发射基地的Ariane-5运载火箭一起成功发射,并与Thales Alenia Space的Eutelsat Konnect卫星一起发射

倾听人们的心声一直是精神病学的核心。一旦确定某名患者患有精神疾病,就必须追踪各个临床阶段的变化,以判断他们的病情是否有所改善或恶化

在周日SpaceX的乘员龙成功安全中止测试之后,埃隆·马斯克(Elon Musk)准备在今年第二季度向国际空间站(ISS)进行首次载人飞行飞行时,搭载N

鸭嘴鸭嘴兽是地球上最奇怪的生物之一,它的外观只是它的一方面。这种独特的哺乳动物只是已知存在卵子的五个现存物种之一,被认为是缺失的一

自2006年以来,美国国家航空航天局(NASA)的火星侦察轨道器(MRO)一直跟踪火星景观的变化。在过去的十年中,MRO上的HiRISE摄像机一直在监视In

我们每天都看到鸟类。窥视窗外,您很有可能会找到一个巡航的羽毛羽毛朋友。人类研究鸟类已有数百年的历史,但是,科学家们一直在努力复制鸟
我们经常想象在火星和其他行星上的未来,是由金属城市和飞行汽车所驱动的。但是现实可能有所不同,也许更环保。美国宇航局(NASA)不再使用金

今天,我们学术环境的数字化已经改变了教育的面貌。几乎每个学生都可以通过稳定的互联网连接访问手机。它不仅可以帮助他们更好地学习,还可

我们正在听到埃隆·马斯克(Elon Musk)雄心勃勃的计划,计划在火星上停留一段时间。最近,SpaceX首席执行官分享了一系列推文,讨论了他的计

地球最早的土地,炎热而地狱,是从上方遮挡的。研究人员发现了更多证据,证明我们的星球在42亿年前就具有强磁场,比以前想象的要早十亿分之

据中国官方官方媒体新华社报道,世界上最大,最灵敏的射电望远镜已经正式营业。FAST射电望远镜在2016年获得了先机,但从那时起一直在进行测

在佛罗里达州卡纳维拉尔角肯尼迪航天中心的39A号发射场,SpaceX对他们的乘员龙号太空舱进行了最后一次未经测试的试验。这是最重要的飞行中